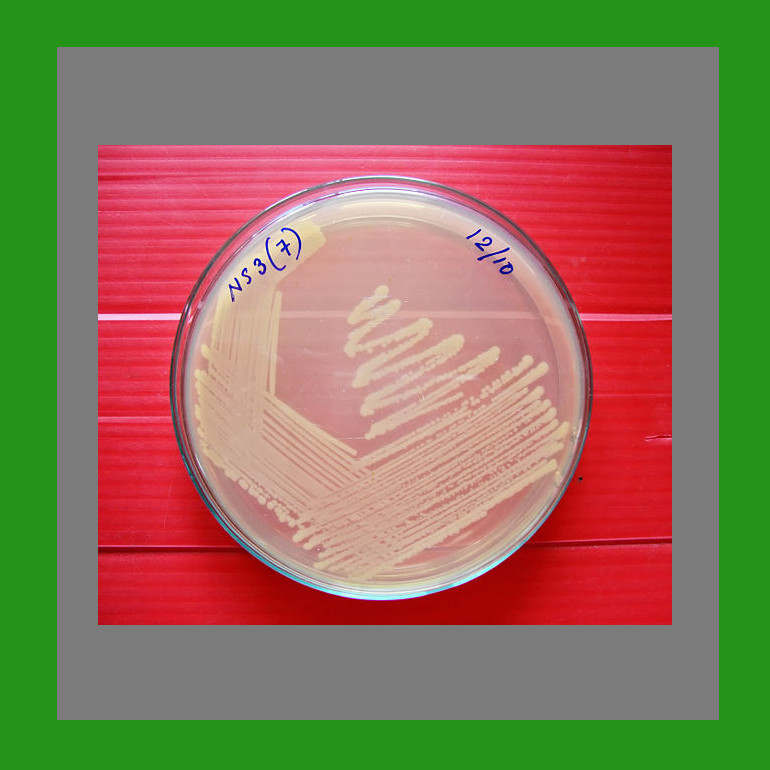

11 questions au régulateur ANSM

Attentat et laboratoires d’état

Un besoin de loi comme en 1975

Le film : court et percutant

Loi spécifique pour péril spécifique
La résistance des bactéries aux antibiotiques

Quelle histoire pour la phagothérapie ?
